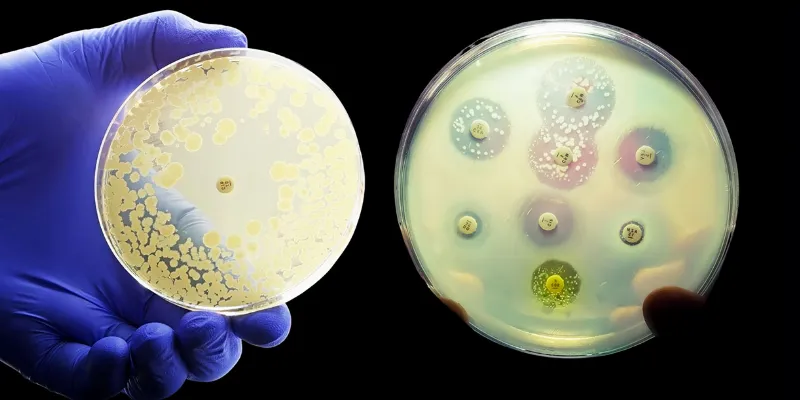

New Study Reveals Evolutionary 'U-turn' in the Fight Against Antibiotic Resistance
8 January 2024
Researchers have made a significant leap in the fight against antibiotic resistance, challenging a long-held belief in evolutionary biology. They discovered that antibiotic resistance, traditionally thought to be irreversible, can potentially be reversed, suggesting that traits once lost might indeed be regained.
In a groundbreaking study published in Nature Ecology & Evolution, scientists from Monash University have introduced a novel concept of 'molecular reverse evolution' in antibiotic resistance. Focusing on Helicobacter pylori, their research revealed that antibiotic-resistant genes can revert to a sensitive state. This discovery not only challenges established evolutionary biology theories but also offers new hope in combating drug-resistant infections.
For years, the principle known as Dollo's Law has guided our understanding of evolution, suggesting that once an organism loses a trait, it cannot regain it. However, this new research challenges this concept by presenting the first-known example of molecular reverse evolution in antibiotic resistance. The lead author, Associate Professor Mike McDonald from the Monash University School of Biological Sciences, highlights the groundbreaking nature of this discovery, opening new avenues in the battle against antibiotic resistance.
The research team focused on the bacterium Helicobacter pylori, known for its capacity for horizontal gene transfer (HGT) – the exchange of DNA between bacteria. Through meticulous tracking and sequencing of genetic alterations in bacterial populations, the researchers observed an unexpected phenomenon: in some instances, antibiotic-resistant gene variants reverted to their original, sensitive state.
The study implies that the evolutionary process, long thought to be a one-way street, can potentially be reversed under certain conditions. The study's emphasis on recombination – the shuffling and exchange of genetic material – as a facilitator of this 'evolutionary U-turn' provides crucial insights into the mechanisms driving these changes.
To further understand the interplay of natural selection, HGT, and the fitness costs of antibiotic resistance, the Monash team constructed a comprehensive population genetic model. Their simulations revealed that, despite the significant costs associated with resistance, a moderate to high level of HGT could render previously resistant bacteria susceptible to antibiotics once again.
This research not only challenges the prevailing wisdom regarding irreversible traits in evolution but also illuminates a path forward in our ongoing struggle against antibiotic resistance.
Abstract of the research
Horizontal gene transfer facilitates the molecular reverse-evolution of antibiotic sensitivity in experimental populations of H. pylori
Abstract: Reversing the evolution of traits harmful to humans, such as antimicrobial resistance, is a key ambition of applied evolutionary biology. A major impediment to reverse evolution is the relatively low spontaneous mutation rates that revert evolved genotypes back to their ancestral state. However, the repeated re-introduction of ancestral alleles by horizontal gene transfer (HGT) could make reverse evolution likely. Here we evolve populations of an antibiotic-resistant strain of Helicobacter pylori in growth conditions without antibiotics while introducing an ancestral antibiotic-sensitive allele by HGT. We evaluate reverse evolution using DNA sequencing and find that HGT facilitates the molecular reverse evolution of the antibiotic resistance allele, and that selection for high rates of HGT drives the evolution of increased HGT rates in low-HGT treatment populations. Finally, we use a theoretical model and carry out simulations to infer how the fitness costs of antibiotic resistance, rates of HGT and effects of genetic drift interact to determine the probability and predictability of reverse evolution.





Comments
No Comments Yet!